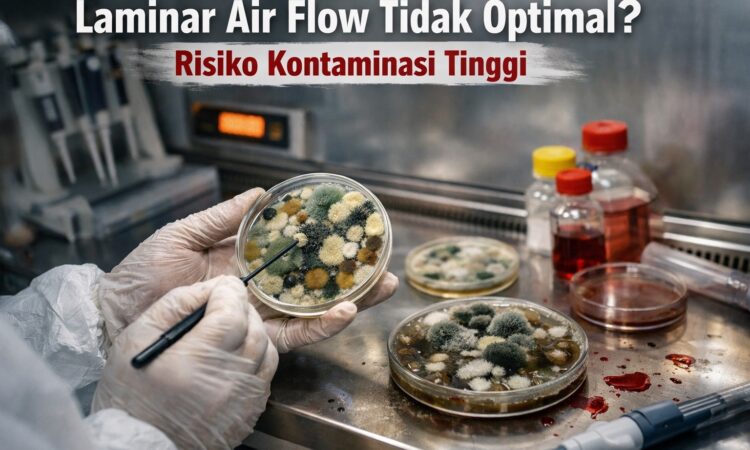

🧼 Peran Penting Laminar Air Flow dalam Laboratorium
Laminar Air Flow (LAF) merupakan alat penting dalam laboratorium yang berfungsi untuk menjaga area kerja tetap steril dengan aliran udara bersih dan terkontrol.
Alat ini banyak digunakan dalam:
- mikrobiologi
- farmasi
- industri makanan
- laboratorium pengujian
Namun, masalah yang sering terjadi adalah laminar air flow tidak optimal, seperti airflow melemah atau filtrasi tidak maksimal.
Masalah ini sangat berbahaya karena sering tidak terlihat secara langsung.
👉 Untuk memahami pentingnya kondisi alat secara keseluruhan, baca juga:
Perbaikan Alat Laboratorium: Jangan Tunggu Rusak Total, Ini Risiko dan Solusinya
⚠️ Risiko Laminar Air Flow Tidak Optimal
Jika LAF tidak bekerja optimal, maka dapat menyebabkan:
1. Kontaminasi Sampel
Udara yang tidak bersih dapat membawa partikel dan mikroorganisme ke dalam area kerja.
2. Hasil Uji Tidak Valid
Kontaminasi dapat menyebabkan hasil pengujian tidak akurat.
3. Risiko Gagal Audit
Dalam standar ISO/IEC 17025, kondisi lingkungan kerja harus terkontrol.
4. Penurunan Kualitas Produk / Pengujian
Terutama pada industri farmasi dan makanan.
🔍 Penyebab Laminar Air Flow Tidak Optimal
Beberapa penyebab utama:
🌬️ 1. HEPA Filter Kotor atau Rusak
Filter yang tidak optimal tidak mampu menyaring partikel dengan baik.
🌀 2. Blower Melemah
Blower yang lemah menyebabkan airflow tidak stabil.
⚙️ 3. Sistem Airflow Terganggu
Distribusi udara tidak merata di area kerja.
🔌 4. Gangguan Kelistrikan
Tegangan tidak stabil mempengaruhi performa alat.
🧼 5. Kurangnya Maintenance
Tidak dilakukan penggantian filter secara berkala.
👉 Baca juga:
5 Tanda Alat Laboratorium Harus Segera Diservice
🛠️ Cara Mengatasi Laminar Air Flow Tidak Optimal
✔ 1. Cek Airflow
Pastikan aliran udara stabil dan merata.
✔ 2. Ganti HEPA Filter
Jika filter sudah kotor atau tidak efektif.
✔ 3. Periksa Blower
Pastikan blower bekerja optimal.
✔ 4. Lakukan Maintenance Berkala
Untuk menjaga performa alat tetap optimal.
✔ 5. Gunakan Teknisi Profesional
Agar sistem tetap sesuai standar laboratorium.
💼 Solusi Service Laminar Air Flow
Jika LAF Anda mengalami:
- airflow tidak stabil
- filter kotor
- blower lemah
- alat tidak bekerja optimal
👉 maka diperlukan service laminar air flow oleh teknisi berpengalaman.
Kami menyediakan layanan:
- pengecekan & diagnosa LAF
- penggantian HEPA filter
- perbaikan blower
- perbaikan sistem airflow
- maintenance rutin
🔗 Hubungan dengan Alat Lain
Masalah performa alat juga terjadi pada:
- oven → tidak panas
- furnace → tidak stabil
- incubator → tidak berfungsi
- waterbath → tidak presisi
- hotplate → tidak panas
👉 Baca juga:
- Oven Laboratorium Tidak Panas
- Furnace Tidak Stabil
- Incubator Tidak Berfungsi
- Waterbath Tidak Presisi
- Hotplate Tidak Panas atau Tidak Berputar
📞 Konsultasi & Diagnosa Awal GRATIS
Kami telah membantu berbagai laboratorium dalam menjaga performa laminar air flow dan alat lainnya.
Jika Anda mengalami:
- laminar air flow tidak optimal
- risiko kontaminasi meningkat
- airflow tidak stabil
👉 Anda dapat mengirimkan foto atau video alat untuk diagnosa awal tanpa biaya.
🚀 Jadwalkan Service Sekarang
Laminar air flow yang tidak optimal dapat menyebabkan kontaminasi dan kerugian besar.
👉 Jangan tunggu sampai hasil uji gagal.
Segera lakukan pengecekan dan perbaikan.
Tim Teknis Solusi ISO Produktivitas siap membantu Anda.
📞 WhatsApp: 08112639648
🌐 Website: solusiisoproduktivitas.com
🔚 Kesimpulan
Laminar air flow yang tidak optimal merupakan risiko besar bagi kualitas pengujian dan kebersihan laboratorium.
Melakukan maintenance dan perbaikan secara berkala adalah langkah penting untuk menjaga hasil tetap valid dan bebas kontaminasi.